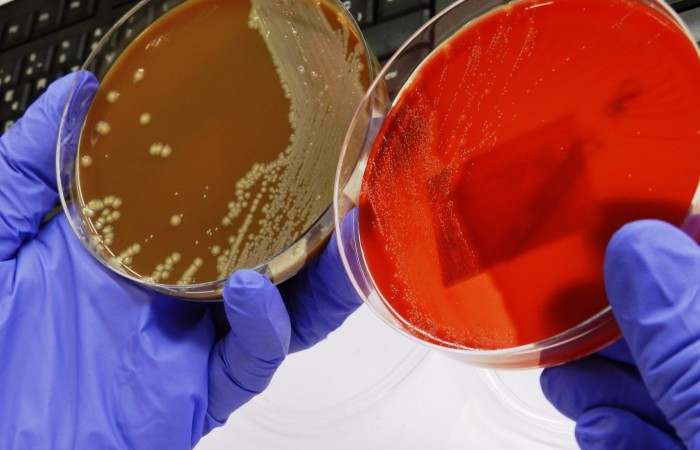
Lectura de cultivos. Laboratori de Refer+¿ncia de Catalunya

Interuniversitari Universitat de Barcelona (UB), Universitat Autònoma de Barelona (UAB) i Universitat Pompeu Fabra (UPF)
Esta web utiliza cookies propias y de terceros para analizar y mejorar tu experiencia de navegación.
Al continuar navegando, entendemos que aceptas su uso.
Acepto